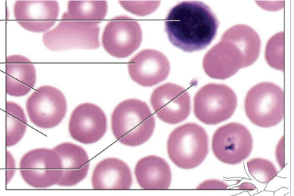
knowt flashcard image

1/10
Looks like no tags are added yet.
Name | Mastery | Learn | Test | Matching | Spaced |
|---|
No study sessions yet.
Areolar connective tissue

adipose connective tissue

reticular connective tissue
lol

dense regular connective tissue

dense irregular connective tissue
wait

elastic connective tissue

hyaline cartilage

elastic cartilage

fibrocartilage

bone

blood